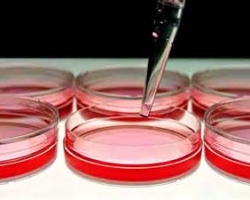

Dall’Italia la prima terapia genica, che corregge il Dna
Arriva in commercio il primo farmaco basato sulla terapia genica, che corregge il Dna, curando una malattia rara
La terapia genica, che ha l’obiettivo di correggere il Dna, per la cura di malattia incurabili, è il grande sogno della scienza. E da ora, questo sogno, in parte si avvera: arriva in commercio il primo farmaco che punta a combattere una malattia estremamente rara che conta meno di 1.000 pazienti in tutta Europa e circa 60-90 in Italia. Lo ha realizzato l’azienda italiana di Chiesi.
La malattia, il deficit di lipoproteina lipasi (Lpld), provoca un grave squilibrio degli acidi grassi, danneggiando gli organi e provocando pancreatiti acute, che portano a morte nel 7-30% dei casi. In particolare la terapia consiste nell’usare uno speciale virus inoffensivo e modificato in laboratorio. Al suo interno è inserito un gene che, una volta entrato nelle cellule del paziente, è in grado di far sintetizzare una proteina che in questi malati non viene prodotta. Con la terapia si corregge il difetto genetico della persona, e secondo gli studi ‘è in grado di ridurre gli attacchi di pancreatite acuta del 54%, e gli attacchi di dolore addominale causati da pancreatite del 59%’.
‘Finora non esistevano cure se non il tentativo di controllare gli acidi grassi con la dieta. Ma parliamo di persone che, su un limite normale di 150, arrivano ad accumulare trigliceridi fino a valori di 5mila, o addirittura 15mila’, spiega Diego Ardigò, responsabile Terapie Avanzate della Chiesi.
Al momento, il medicinale non si rivolge a tutti i malati con Lpld, ma solo a quelli che sono a uno stadio molto grave.
gc




sbo
… [Trackback]
[…] Read More to that Topic: ecoseven.net/canali/scienze/dall-italia-la-prima-terapia-genica-che-corregge-il-dna/ […]
hillapple.bet
… [Trackback]
[…] Info on that Topic: ecoseven.net/canali/scienze/dall-italia-la-prima-terapia-genica-che-corregge-il-dna/ […]
limanbet giriş
… [Trackback]
[…] Read More here on that Topic: ecoseven.net/canali/scienze/dall-italia-la-prima-terapia-genica-che-corregge-il-dna/ […]
Dividend
… [Trackback]
[…] Here you can find 51137 additional Info to that Topic: ecoseven.net/canali/scienze/dall-italia-la-prima-terapia-genica-che-corregge-il-dna/ […]
เอสบีโอเบท
… [Trackback]
[…] Here you can find 45284 more Information to that Topic: ecoseven.net/canali/scienze/dall-italia-la-prima-terapia-genica-che-corregge-il-dna/ […]